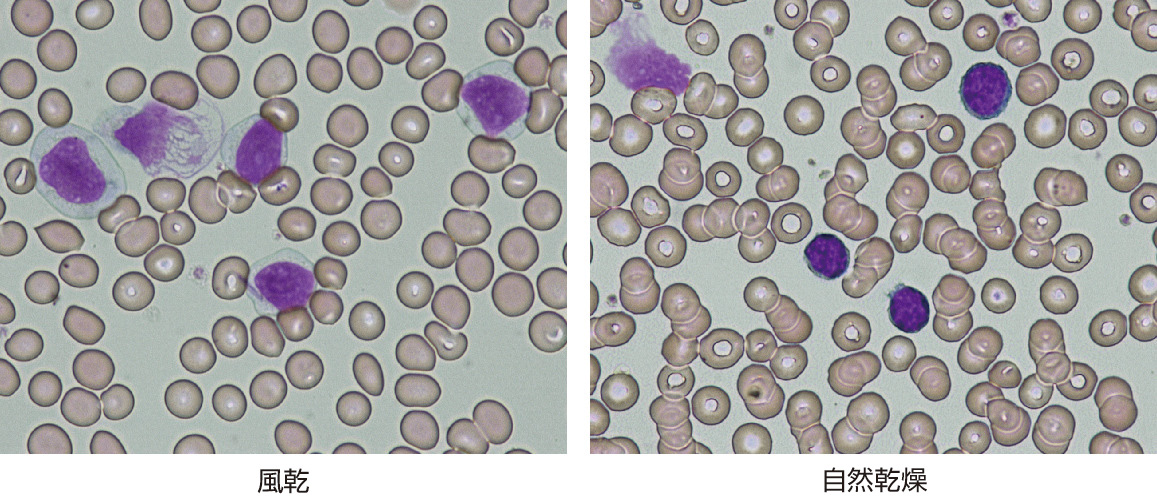

ⓔコラム17-10-7 CLLの鑑別診断
マージナルゾーンリンパ腫では,ときにCD5陽性CD23陽性の症例もあるとされ,本症では特異的な遺伝的マーカーがないことよりCLLと診断されている例に含まれている可能性がある1).ヘアリー (hairy) 細胞白血病は,特異的マーカーとしてCD103,CD25,CD11c陽性でCD5,CD23陰性であること,遺伝子異常としてほぼすべての症例にBRAFV600E変異を認めること,特徴的な形態を示すことなどからCLLとの鑑別は難しくない2).前リンパ球性白血病は,大型で核小体を有し,胞体の好塩基性が強い細胞であること,CD5,CD23陰性であることなどから鑑別できるが,CLLでも白血病細胞に前リンパ球が混在することがありその比率が55%未満の場合は非典型CLL (CLL/PL) と診断する3,4).
ところで,日本では塗抹標本を作製する場合,塗抹後すぐに冷風で乾燥させる (風乾) ことが行われている.これは,実は日本独特の作製方法で,日本以外では塗抹後放置して乾燥させる方法 (自然乾燥) が一般的である.CLL細胞は,小型リンパ球であることが形態学的には特徴であることは先に述べたが,細胞の大きさの判定は自然乾燥標本の観察で定義されている.なぜならば,日本で行われている風乾では,細胞質が広がった状態でスライドグラスに張りつくため,細胞は大きくなり,また細胞表面の突起や絨毛様構造はわかりにくくなるのである.したがって,CLLの診断・鑑別診断を行う場合,必ず自然乾燥標本も作製して観察することが重要である5).図1に同一症例の風乾と自然乾燥標本の形態を示す.風乾では細胞質が広く小型リンパ球とはいえないが,自然乾燥標本では典型的なCLL細胞である.
CLLの診断に欠かすことのできないのはフローサイトメトリー (flow cytometry: FCM) を用いたマーカー解析である.図2に典型例のFCM解析結果を示す.CD5,CD23陽性が最も特異的な特徴であるが,これらが陽性でも症例によってはCD20,CD22,smIgなどのB細胞受容体関連抗原が強く発現されていることがある.このような例でも形態的に矛盾がなく,他のB細胞腫瘍に特徴的なマーカーが陰性であれば,CLLと診断してよい6,7).

〔青木定夫〕
■文献
Piris MA, Pittaluga S, et al: Splenic marginal zone lymphoma. WHO classification of tumours of haematopoietic and lymphoid tissues revised 4th ed (Swerdlow SH, Campo E, et al eds), IARC, 2017; 223–225.
Foucar K, Falini B, et al: Hairy cell leukaemia. WHO classification of tumours of haematopoietic and lymphoid tissues revised 4th ed (Swerdlow SH, Campo E, et al eds), IARC, 2017; 226–228.
Bennett JM, Catovsky D, et al: Proposals for the classification of chronic (mature) B and T lymphoid leukaemias. French–American–British (FAB) Cooperative Group. J Clin Pathol, 1989; 42: 567–484.
Campo E, Harris NL, et al: B–cell prolymphocytic leukaemia. WHO classification of tumours of haematopoietic and lymphoid tissues revised 4th ed (Swerdlow SH, Campo E, et al eds), IARC, 2017; 222–223.
青木定夫:CLLの形態観察における乾燥法の違いについて.日本検査血液学会誌,2014; 15: 396–413.
Hallek M, Cheson BD, et al: iwCLL guidelines for diagnosis, indications for treatment, response assessment, and supportive management of CLL. Blood, 2018; 131: 2745–2560.
青木定夫:慢性リンパ性白血病/小リンパ球性リンパ腫.WHO分類改定第4版による白血病・リンパ系腫瘍の病態学 (木崎昌弘,田丸純一編),中外医学社,2019; 220–227.